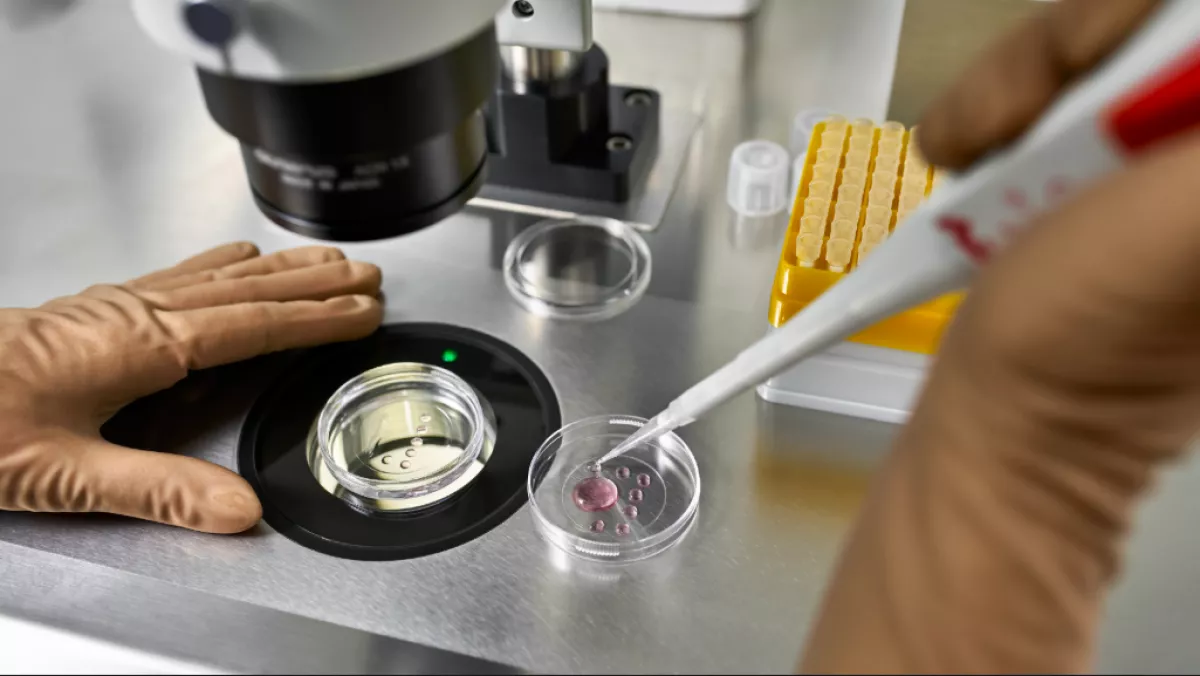
Lombikbébi program után: amikor meglátta a babát, azonnal DNS-tesztet követelt

Lombikbébi program után: amikor meglátta a babát, azonnal DNS-tesztet követelt
Amikor világra jött a kislány, a szülők rögtön érezték, itt valami nagyon nincs rendben. A DNS-teszt mindent megerősített.
Sokk
Az Egyesült Államokban egy nő egy ismeretlen pár gyermekének adott életet – akaratlanul. A szörnyű félreértésre akkor derült fény, amikor a szülés után DNS-tesztet végeztek, amelyből kiderült, hogy az újszülött biológiailag egyik szülővel sem rokon.
Pert indított a pár
Minden akkor kezdődött, amikor a pár 2025 márciusában úgy döntött, hogy lombikbébi-programnak veti alá magát egy orlandói meddőségi klinikán. A kezelés során a nő azt hitte, hogy a saját petesejtjét ültették be, amelyet a testén kívül termékenyítettek meg partnere spermájával. A szülők csak akkor vették észre, hogy a klinika szörnyű hibát követett el, amikor lányuk tavaly decemberben megszületett. Amikor először meglátták a csecsemőt, rögtön észrevették, hogy a lány „nem kaukázusi gyermek megjelenésével” rendelkezik – áll a People magazin által a felperesek ügyvédjén keresztül megszerzett hivatalos beadványban.
















